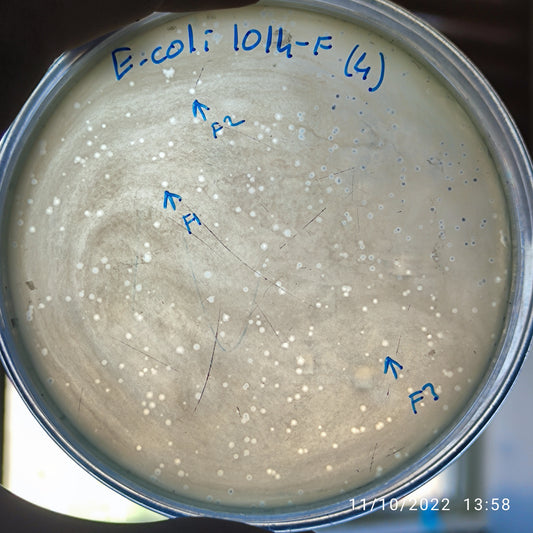
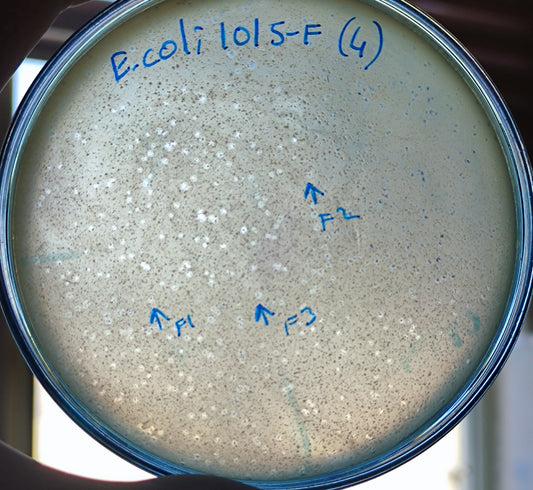
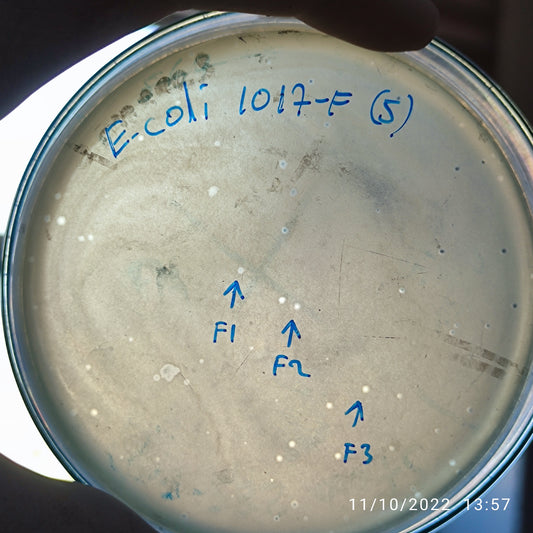
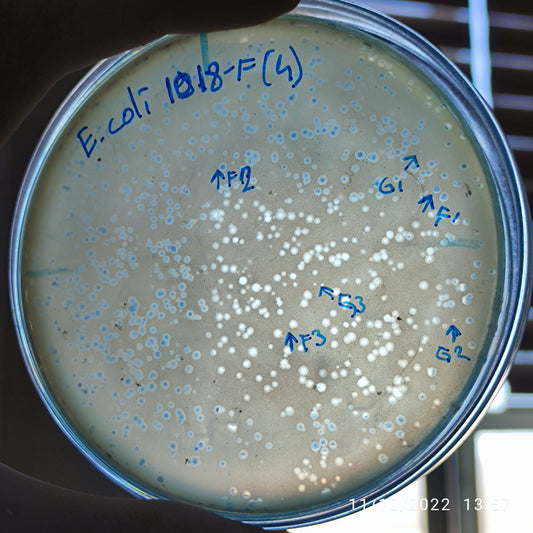
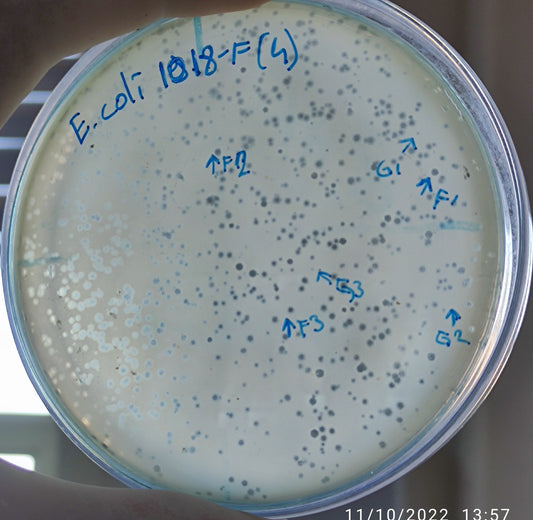
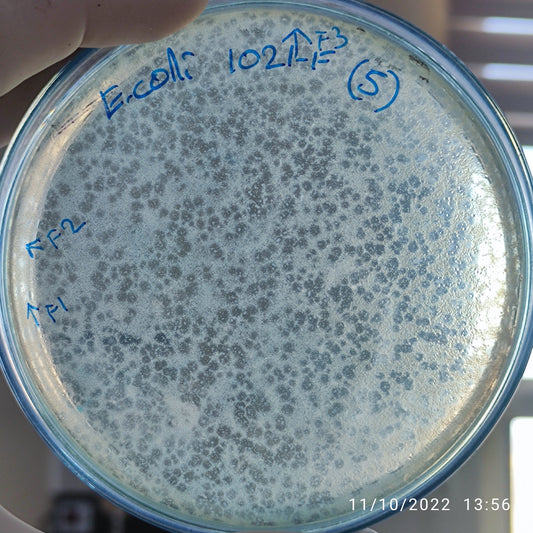
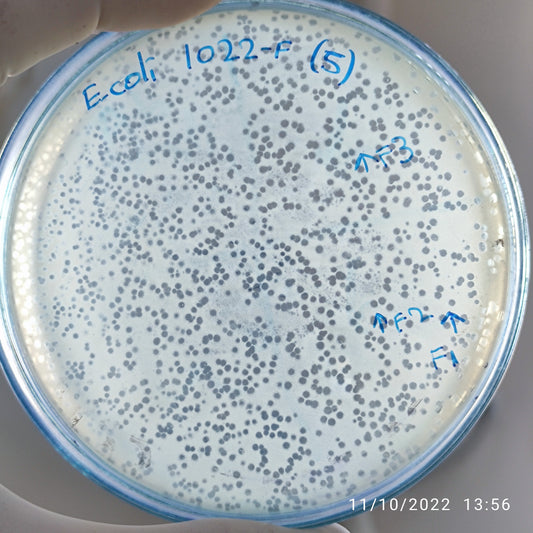
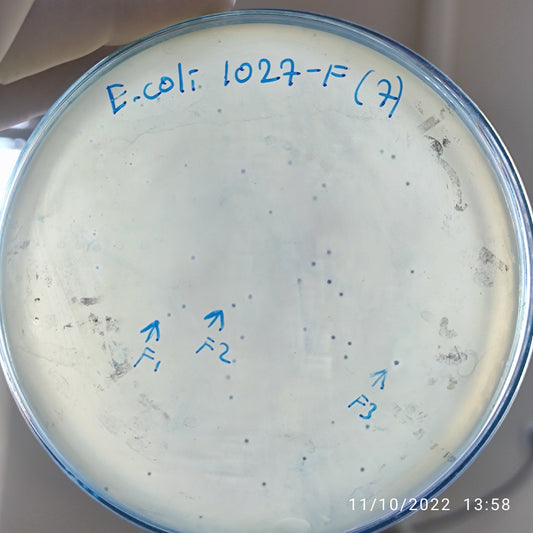
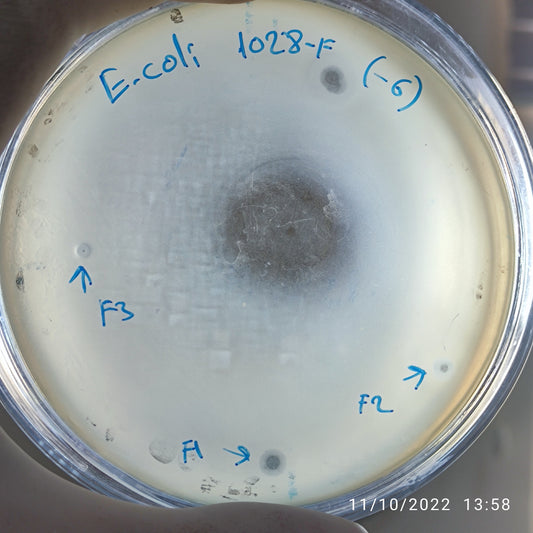

-
Escherichia coli bacteriophage 101012F
Regular price $500.00 USDRegular priceUnit price per -
Escherichia coli bacteriophage 101013F
Regular price $500.00 USDRegular priceUnit price per -
Escherichia coli bacteriophage 101014F
Regular price $850.00 USDRegular priceUnit price per -
Escherichia coli bacteriophage 101015F
Regular price $850.00 USDRegular priceUnit price per -
Escherichia coli bacteriophage 101017F
Regular price $800.00 USDRegular priceUnit price per -
Escherichia coli bacteriophage 101018F
Regular price $800.00 USDRegular priceUnit price per -
Escherichia coli bacteriophage 101018G
Regular price $650.00 USDRegular priceUnit price per -
Escherichia coli bacteriophage 101021F
Regular price $800.00 USDRegular priceUnit price per -
Escherichia coli bacteriophage 101022F
Regular price $900.00 USDRegular priceUnit price per -
Escherichia coli bacteriophage 101023F
Regular price $750.00 USDRegular priceUnit price per -
Escherichia coli bacteriophage 101023G
Regular price $750.00 USDRegular priceUnit price per -
Escherichia coli bacteriophage 101024F
Regular price $500.00 USDRegular priceUnit price per -
Escherichia coli bacteriophage 101026F
Regular price $900.00 USDRegular priceUnit price per -
Escherichia coli bacteriophage 101026G
Regular price $850.00 USDRegular priceUnit price per -
Escherichia coli bacteriophage 101027F
Regular price $750.00 USDRegular priceUnit price per -
Escherichia coli bacteriophage 101028F
Regular price $900.00 USDRegular priceUnit price per